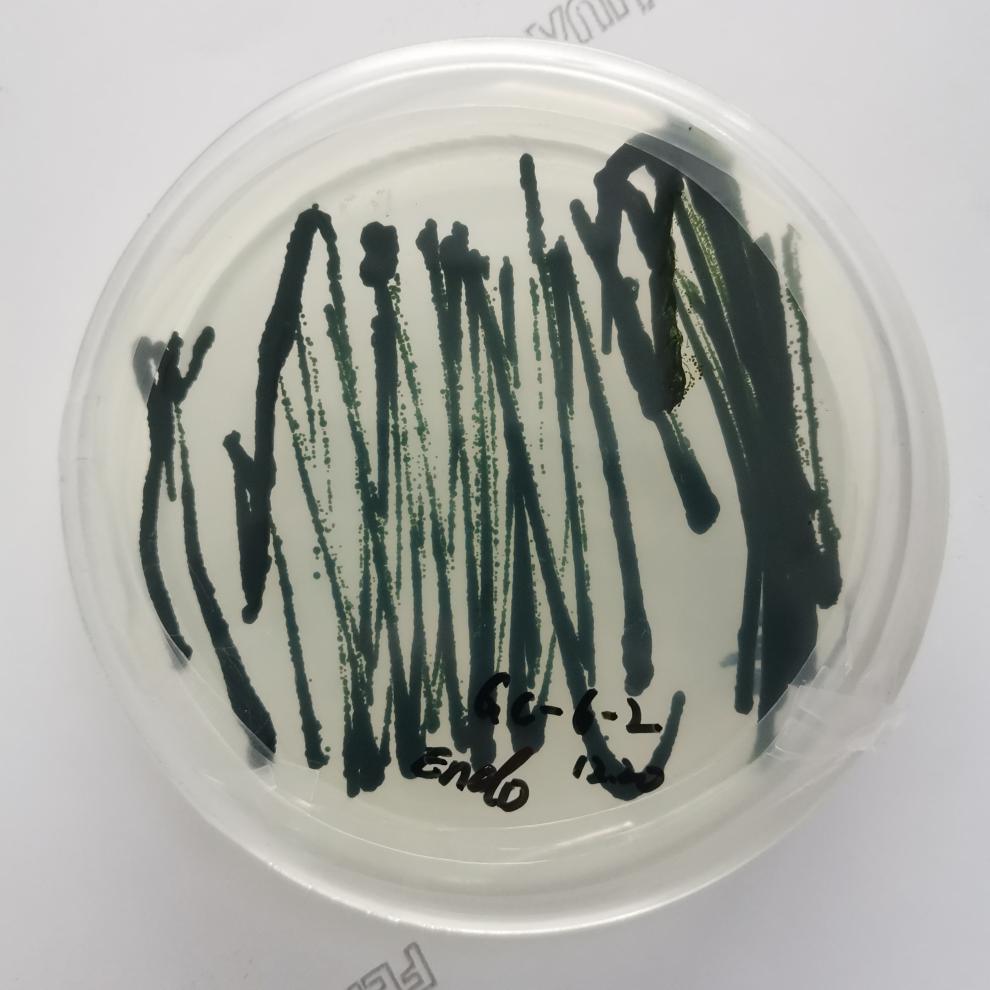
小球藻藻种水产养殖肥水培藻肥水藻海水小球藻培养基定制淡水藻原液1

小球藻种

小球藻种
图片尺寸750x6352
这款小球藻,优质藻种,高活高浓度可扩培
图片尺寸720x952
小球藻硅藻种
图片尺寸800x800
小球藻藻种浓缩复合硅藻种水产养殖鱼塘用肥水培藻增氧藻类培玉满
图片尺寸800x800
《藻种源》优势: 1,快培速养中水需要的小球藻,卵囊 - 抖音
图片尺寸1080x1749
小球藻藻种水产养殖肥水培藻肥水藻海水小球藻培养基定制淡水藻原液1
图片尺寸790x938
绿色视野#
图片尺寸600x340
养殖常备 培水增氧 保苗促长 球藻种 小球藻种 小球藻种(浓 - 抖音
图片尺寸800x800
小球藻藻种浓缩复合硅藻种水产养殖鱼塘用肥水培藻增氧藻类培玉满
图片尺寸800x800
小球藻对絮凝预处理沼液的适应性及净化效果
图片尺寸640x461
本文将介绍小球藻的特点,分布,生长环境,生态意义和对人类的意义.
图片尺寸640x521
小球藻种养鱼养龟绿水蛋白核培养基调水改水族鱼虾活体增氧养鱼病
图片尺寸350x350
solelybio sbm0417 小球藻藻种 200ml
图片尺寸450x450
小球藻如何在池塘快速培养
图片尺寸640x425
小球藻如何在池塘快速培养?
图片尺寸1920x1280
小球藻藻种水产养殖肥水培藻肥水藻海水小球藻培养基定制淡水藻原液1
图片尺寸990x990
华畜小球藻藻种增氧鱼塘虾蟹贝塘水产养殖开口饵料绿水藻种肥水培藻藻
图片尺寸790x1509
夏季小球藻就用鱼耀的高活性藻种一袋5亩不用添加其他肥料方便省 - 抖
图片尺寸1440x1920
华畜小球藻种5l 快速肥水光合产氧 补充有益藻
图片尺寸800x800
小球藻
图片尺寸2992x2992